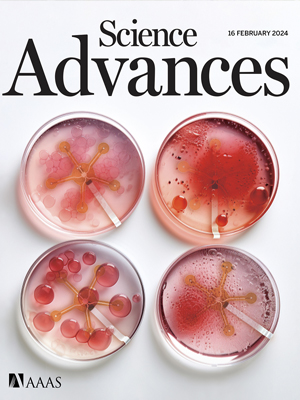
Science Advances journal cover

Epigenase™ HDAC Activity/Inhibition Direct Assay Kit
Measure total activity/inhibition of HDAC enzymes in nuclear extracts or purified HDAC isoforms (HDACs 1–11).
Streamlined HDAC Assay with High Sensitivity


ELISA-like kits to measure HDAC activity or inhibition using nuclear extracts or purified enzyme from a broad range of species — results in ~3 h 30 min.
- Fast & simple: Complete the entire procedure in just 3 hours 30 minutes.
- Direct detection: Measures HDAC-converted deacetylated products — no trypsin-based peptide cleavage.
- Versatile: Works with cell/tissue extracts or purified HDAC enzymes, enabling detection of inhibitor effects in vivo and in vitro.
- Sensitive: Detects activity from as little as 0.5 ng of purified HDAC enzyme.
- Reliable: Includes a potent class I/II HDAC inhibitor as a positive control.
- Flexible: Strip-well microplate format suitable for manual or high-throughput analysis.
- Proven & trusted: Highly cited in over 100 peer-reviewed studies.
Whether you’re testing a few samples or large batches, this HDAC assay delivers consistent, dependable results with unmatched convenience.
HDAC Activity/Inhibition Direct Assay Epigenase™ User Guide Video
Featured in the World’s Leading Scientific Journals:
Our HDAC Activity/Inhibition Direct Assay Kit is trusted by leading researchers and highly cited in top-tier publications with high impact factors, fueling groundbreaking discoveries.

Impact Factor: 50.5
Jin J et al. (Nov 2024). Human HDAC6 senses valine abundancy to regulate DNA damage. Nature.

Impact Factor: 17.7
Li X et al. (Dec 2021). The methyltransferase METTL3 negatively regulates NASH progression. Nat Commun.

Impact Factor: 15.9
Ma N et al. (Jun 2025). Regulation of m6A reader OsECT3 by lysine acetylation under cold stress. Nat Plants.
Impact Factor: 15.1
Song Y et al. (Feb 2024). Biphasic regulation of epigenetic state by matrix stiffness during reprogramming. Sci Adv.
Get Ready For Fast & Simple HDAC Activity Quantification
View Product DetailsFrequently Asked Questions
What does this HDAC kit measure?
Total activity or inhibition of classical (Zn2+-dependent) HDACs—Classes I, II, and IV—via direct colorimetric readout of deacetylated products.
Does it detect sirtuins (Class III)?
No. It’s optimized for HDAC1–11. Use a sirtuin-specific assay for SIRT1–7.
Compatible sample types?
Nuclear extracts or purified HDAC isoforms from multiple species; compatible with cultured cells and tissues.
Sensitivity / amount needed?
Detects as little as 0.5 ng purified HDAC. For screening, use ~5–20 ng per well.
Assay time?
About 3.5 hours.



 Cart (0)
Cart (0)






